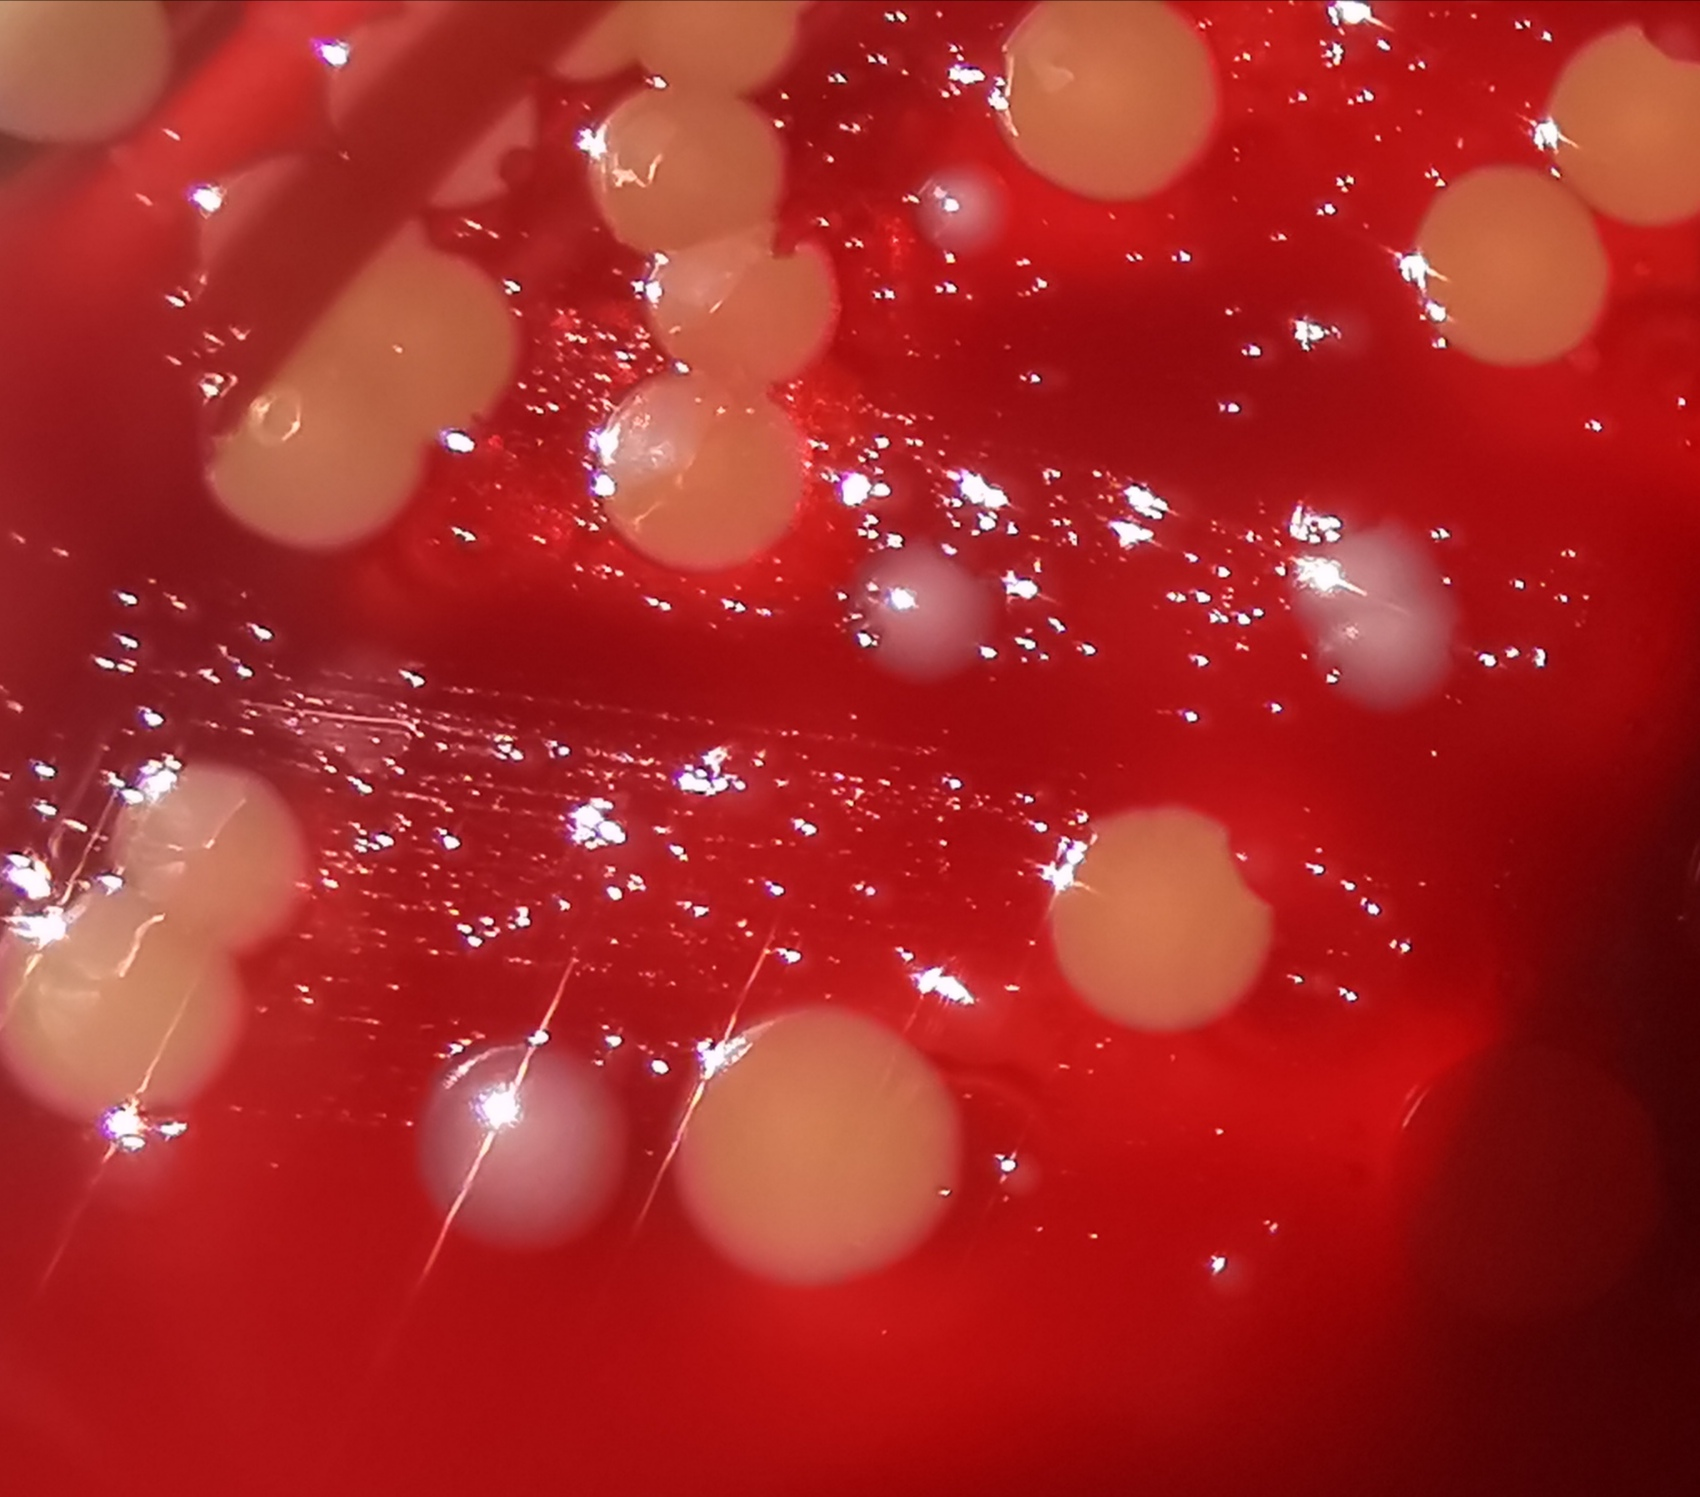
figura1 difterite

A volte ritornano! La difterite, patologia riemergente negli anni Venti del Duemila
Autori:
- Simona Barnini - Azienda ospedaliero-universitaria pisana
- Fabrizio Gemmi - Agenzia regionale di sanità della Toscana
Indice
- Breve sintesi sulla patologia e sugli agenti eziologici
- La tossina e gli altri fattori di patogenicità
- Il vaccino
- Diagnosi microbiologica
- Epidemiologia e coperture vaccinali nel mondo
- La situazione in Europa
- In prospettiva
1. Breve sintesi sulla patologia e sugli agenti eziologici
La difterite è una grave infezione, potenzialmente letale, causata da batteri Gram positivi (Corynebacterium diphtheriae e, raramente, altre specie di Corynebacterium, come C. ulcerans e C. pseudotuberculosis) che producono una tossina, la tossina difterica, causa della gravità della patologia [1,2].
C. diphtheriae è un bacillo aerobio, noto come bacillo di Klebs-Löeffler, in quanto scoperto da Klebs nel 1883 e coltivato da Löeffler, che ne dimostrò la tossigenicità l’anno seguente. Prende il nome dal greco antico dìftera, che significa pelle, cuoio, o anche tenda militare, per le caratteristiche pseudomembrane che produce al sito di infezione. Ceppi non tossigeni di C. diphtheriae e altri membri del genere Corynebacterium sono considerati patogeni emergenti, in quanto capaci di provocare malattia non prevenibile mediante il vaccino [3]. La malattia infatti è prevenibile con un vaccino costituito dalla tossina modificata (tossoide), comunemente somministrato insieme ai vaccini antitetanico e antipertosse.
C. diphtheriae viene distinto in quattro biotipi o biovar, basandosi sulla morfologia della colonia e sulle caratteristiche biochimiche: gravis, mitis, intermedius e belfanti, quest’ultimo raramente tossigeno. Gli altri tre biotipi sono chiamati così in assonanza con la gravità della malattia che sono capaci di evocare.
La diffusione interpersonale dei batteri della difterite avviene di solito attraverso goccioline respiratorie (droplets), soprattutto tramite colpi di tosse o starnuti, essendo il naso la porta d’entrata del batterio nell’ospite e la bocca la porta d’uscita. Le persone possono anche ammalarsi per contatto diretto con ferite o ulcere infette o con oggetti contaminati. Quelle a maggior rischio di contagio includono:
- persone conviventi di malati
- persone con una storia di contatto stretto con il paziente
- persone direttamente esposte alle secrezioni dal sito sospetto di infezione del paziente
La difterite può localizzarsi alle vie respiratorie e alla cute. I sintomi dipendono dalla sede interessata, con periodo di incubazione da 2 a 5 giorni.
L’apparato respiratorio rappresenta la sede più frequentemente colpita (difterite respiratoria). I batteri aderiscono alle mucose, causando debolezza, febbre, ingrandimento dei linfonodi cervicali e mal di gola. La tossina prodotta ha effetto necrotizzante sui tessuti colpiti, precedentemente sani. Entro due o tre giorni, la necrosi tissutale causata dalla tossina forma uno spesso rivestimento grigio, la pseudomembrana, appunto, che può accumularsi nei tessuti del naso, delle tonsille, del laringe e della gola, rendendo molto difficile respirare e deglutire. Se la tossina entra nel torrente ematico può causare danni al cuore, ai nervi e ai reni.
Anche la cute può essere infettata, con manifestazioni di piaghe aperte o ulcere (difterite cutanea). Tuttavia, le infezioni difteriche cutanee raramente provocano una malattia grave.
2. La tossina e gli altri fattori di patogenicità
L’adesione di C. diphtheriae all’epitelio dell’ospite è mediata da pili, costituiti da piline, proteine fondamentali per l’efficacia del primo contatto, dato che mutazioni in queste molecole diminuiscono la virulenza del batterio. Altre adesine, emoagglutinine e proteine di superficie sono importanti per la patogenicità del ceppo, anche quando si tratta di stipiti non tossigeni ma invasivi, a differenza di quelli tossigeni, i quali permangono al sito di infezione e non invadono il torrente circolatorio, attraverso cui invece la tossina difterica viene distribuita ai tessuti dell’ospite.
Le tossine batteriche che agiscono mediante la ribosilazione di ADP sono un’intera famiglia: agiscono catalizzando l’idrolisi del nicotinammide adenin dinucleotide (NAD) e trasferendone la porzione di ADP-ribosio sulla proteina eucariotica, che rappresenta il bersaglio della tossina. Nel caso della tossina difterica (DT), il bersaglio è il fattore di allungamento 2 (EF-2), attivo nella sintesi proteica della cellula ospite, che viene ADP-ribosilato [4].
DT è il fattore di virulenza principale, per il bacillo difterico; il gene tox è veicolato da un batteriofago ed è integrato nel genoma batterico insieme al genoma del fago. Lo stato di lisogenia fa acquisire anche quello di tossinogenia a C. diphtheriae e ad altre specie affini. La regolazione del gene tox dipende invece dal genoma batterico: il gene per il repressore DtxR, infatti, è sul cromosoma del batterio e codifica per una proteina repressore (DtxR) che regola l’assunzione di ferro mediata da siderofori, l’espressione dell’eme-ossigenasi e DT.
La sequenza a cui si lega la proteina DtxR è vicina al promotore dei geni tox e sid. I siderofori trasportano il ferro nella cellula e l’attività del repressore è controllata dal ferro, il cui attacco provoca un cambiamento allosterico nella proteina repressore DtxR, che blocca efficacemente l’operatore tox. Il ferro agisce quindi come corepressore per l’attacco di DtxR al DNA, e in questo caso non avviene la trascrizione di tox. Il repressore invece è inibito da basse concentrazioni di ferro, che quindi esitano nell’aumento della produzione di DT. A riprova di questo meccanismo, l’inattivazione del repressore provoca l’espressione costitutiva di DT, anche in presenza di alte concentrazioni di ferro, poiché il repressore non è più in grado di cambiare conformazione grazie al ferro e di legarsi alla sequenza dell’operatore, impedendo l’attacco della RNA-polimerasi e quindi la trascrizione del gene tox.
DtxR ha diverse funzioni: protegge la cellula batterica dal danno ossidativo e influenza l’espressione di molti geni. Oltre all’espressione di DT, anche l’aderenza, la colonizzazione dei tessuti dell’ospite e la formazione del biofilm, che porterà alla produzione delle pseudomembrane, dipendono dalla limitazione del ferro disponibile.
L’assorbimento della DT attraverso il sangue circolante provoca principalmente danni al miocardio e ai nervi periferici: miocardite e neuropatie sono le complicanze più frequenti, infatti, e la miocardite è causa di decesso nel 60-70% dei casi, durante la fase acuta della difterite.
La DT risulta letale per l’uomo a dosi bassissime: una sola molecola è sufficiente ad uccidere una cellula umana; tra le sue azioni citotossiche, DT induce la degradazione dei filamenti di actina, causa principale della cardiomiopatia e delle aritmie che è in grado di provocare, fino all’arresto cardiaco. Cardiomiopatia e neuropatia possono essere anche complicanze post-difterite, stavolta di tipo autoimmune, a causa della somiglianza degli epitopi tra la subunità B di DT e il dominio extracellulare del recettore del fattore di crescita epidermico (EGFR).
C. ulcerans causa la forma cutanea di difterite sia nell’uomo che negli animali, i quali possono trasmetterla all’uomo anche se asintomatici. I ceppi tossigeni di C. ulcerans sono lisogeni per un batteriofago diverso da quello di C. diphtheriae. C. ulcerans è geneticamente più affine a C. pseudotuberculosis che a C. diphtheriae, dal quale diverge anche per il gene tox, che può anche non essere trascritto e del quale esistono cinque varianti, in questa specie. C. pseudotuberculosis viene trasmesso all’uomo soprattutto dagli animali e provoca spesso linfoadenite; può essere lisogeno per lo stesso fago di C. diphtheriae.
3. Il vaccino
Il vaccino anti-difterico viene somministrato insieme ad altri vaccini in varie combinazioni. Il vaccino contro la difterite contiene la tossina inattivata (tossoide) adsorbita su un adiuvante, solitamente idrossido di alluminio o fosfato di alluminio.
La formulazione comunemente utilizzata in Italia è la DTPa (difterite-tetano-pertosse acellulare) [5]. Esistono due diverse formulazioni di questa associazione di vaccini:
- quella pediatrica (DTPa) che si somministra fino ai 6 anni
- quella da adulti (dTpa), che si somministra da 7 anni in poi, nella quale le componenti inattivate per la difterite e la pertosse sono presenti in forma ridotta
La potenza del tossoide è misurata in unità internazionali (UI) mediante saggio di provocazione o saggio sierologico su cavia. Secondo le raccomandazioni dell'OMS, la potenza del vaccino contro la difterite utilizzato per l'immunizzazione dei bambini fino a 6 anni di età non deve essere inferiore a 30 UI per dose. Nella formulazione impiegata a partire dai 7 anni di età, la riduzione della potenza del tossoide difterico riduce al minimo la reattogenicità nel sito di iniezione, ma è sufficiente a provocare una risposta anticorpale nei bambini più grandi e negli adulti [6].
La diagnosi clinica di difterite, basata sui segni tipici della malattia, come il collo taurino, provocato dai linfonodi ingrossati, la presenza di spesse pseudomembrane nella faringe posteriore, o le tipiche lesioni rotonde e rilevate nel caso della forma cutanea, deve essere confermata dall’isolamento e dall’identificazione dell’agente etiologico, ossia una delle tre specie di Corynebacterium (diphtheriae, ulcerans, pseudotuberculosis) che producono DT.
La coltura è il gold standard e i tamponi vanno eseguiti dai siti della sospetta infezione; nel caso di pseudomembrane, il tampone va eseguito sotto la membrana stessa, oppure si può prelevare un frammento di membrana. Il terreno di trasporto dovrebbe essere tipo Amies, addizionato di carbone. La coltura si effettua su agar sangue (di pecora o cavallo), o su agar tellurito. Su agar sangue le colonie possono risultare difficili da riconoscere, a causa soprattutto della scarsa consuetudine di questa osservazione nei Paesi dove la vaccinazione è largamente diffusa: sono colonie convesse, grigiastre e traslucenti (figura 1).
Sui terreni al tellurito, blandamente selettivi, il riconoscimento presuntivo è invece facilitato dalla colorazione nerastra delle colonie, dovuta alla riduzione intracellulare del tellurito a tellurio. Va sottolineato, tuttavia, che l’impiego di agar tellurito da parte del laboratorio di Microbiologia sarà possibile solo se è stato manifestato il sospetto clinico e che difficilmente, in ogni caso, il laboratorio avrà a disposizione questo tipo di terreno.
Le colonie di C. ulcerans e di C. pseudotuberculosis possono dare beta-emolisi su agar sangue. Le colonie possono poi essere impiegate per test di conferma presuntiva con test enzimatici che evidenzino caratteristiche biochimiche differenziali fra le specie, ma questi procedimenti, ancora in uso nei Paesi dove la difterite è endemica, sono stati soppiantati dall’uso della spettrometria di massa MALDI-TOF, che ha una accuratezza tra il 97 e il 100% per l’identificazione delle tre specie in questione.
Le colonie isolate possono essere impiegate per la rilevazione del gene tox mediante saggi in PCR e per i saggi di produzione di tossina. Il test impiegato è il test di immunoprecipitazione di Elek, nel quale due ceppi di controllo, uno tossigeno e uno no, e il ceppo da saggiare vengono seminati su una piastra di agar sangue perpendicolarmente ad una striscia di carta bibula imbevuta di antitossina difterica. Se il ceppo in esame è tossigeno, si formeranno legami antigene-anticorpo determinando un precipitato alla linea di equivalenza.
In conclusione, mentre la ricerca del gene tox, in caso di esito negativo, determina la fine delle indagini, la sua presenza non implica necessariamente la produzione di tossina difterica, per accertare la quale va eseguito il test di Elek.
Una volta individuate le colonie, le conferme mediante PCR e test di Elek, nonché la determinazione del biovar, saranno eseguite dal laboratorio di riferimento dell’Istituto superiore di sanità, a cui va inviato il ceppo.
Figura 1. Le colonie grigiastre di Corynebacterium diphtheriae, tra quelle gialline di Staphylococcus aureus, su una piastra di agar sangue (gentile concessione di Alessandro Leonildi, SD Microbiologia batteriologica AOUP)
5. Epidemiologia e coperture vaccinali nel mondo
La vaccinazione contro la difterite ha ridotto drasticamente la mortalità e la morbilità della patologia, che tuttavia costituisce ancora un problema significativo per la salute dei bambini nei Paesi con una scarsa copertura vaccinale infantile.
Nei Paesi in cui è endemica, la malattia si verifica principalmente in casi sporadici o piccoli focolai.
La difterite risulta fatale nel 5-10% dei casi, con letalità più elevata nei bambini piccoli. Il trattamento prevede la somministrazione di antitossina difterica per neutralizzare gli effetti della tossina e di antibiotici per combattere l’infezione .
L’Organizzazione mondiale della sanità (OMS) riporta, a livello globale, tassi di incidenza annuali compresi tra 0,7 e 2 casi per milione di abitanti tra il 2000 e il 2017, corrispondenti a circa 4.300-11.000 casi; nel 2018-2019 l'incidenza è aumentata a 2,4 (16.911 casi) e 3,4 per milione (22.986 casi), rispettivamente. Nell’ultimo biennio (2020-2021) l’incidenza è rientrata a livelli di base.
Precedentemente, tra il 1993 e il 1995, si era registrato un picco epidemico: il maggior contributo a questo fenomeno fu dato dai paesi dell’area orientale della Regione europea dell’OMS (47.874 casi con incidenza di 55,8/1.000.000 nel 1994; 50.433 casi con incidenza 58,6/1.000.000 nel 1995) [8] (figure 2, 3).
Figura 2. Numero di casi di difterite nel mondo e incidenza (casi/1.000.000) anni 1990-2021 (fonte: WHO)

Figura 3. Incidenza di difterite (casi/1.000.000) per regione OMS. Anni 1990-2021 (fonte: WHO)

Nel 2018, invece, il picco di incidenza ha interessato principalmente le regioni OMS del Mediterraneo orientale e dell’Asia, mentre dal 2019 in poi si ha un maggior impatto della Regione africana (figura 4).
Figura 4. Tassi di incidenza di difterite (casi/1.000.000) per regione OMS. Anni 2017-2021 (fonte: WHO)

Il controllo della malattia su scala mondiale è dovuto principalmente alla vaccinazione con il tossoide difterico, in particolare dopo l’introduzione, nel 1974, dello schema di immunizzazione con 3 dosi di vaccino comprendente la combinazione antidifterite, antitetanica e antipertosse (DTP3), che ha raggiunto l'86% di copertura globale nel 2016 (figura 5).
Figura 5. Indici di copertura con 3 dosi di vaccino per difterite, tetano e pertosse (DTP3), per regione OMS. Anni 1990-2021 (fonte: WHO)

Il grafico seguente (figura 6) confronta l’andamento a livello mondiale del numero di casi segnalati e della copertura DTP3, negli anni 1980-2015. Il marcato aumento dei casi a metà degli anni Novanta è dovuto all’epidemia, già ricordata, nei nuovi stati indipendenti dell'ex Unione Sovietica, durata dal 1990 al 1999, che ha causato 157.000 casi e 5.000 morti [9].
Figura 6. Numero di casi di difterite e copertura globale con 3 dosi di vaccino per difterite, tetano e pertosse (DTP3), anni 1980 - 20159 [9].

6. La situazione in Europa
Nel sistema di sorveglianza dell’ECDC, dal 2010 al 2021 sono stati registrati in Europa 276 casi da C. diphtheriae, con 11 decessi, e 238 casi da C. ulcerans, con 4 decessi.
Il maggior numero dei casi è riportato in Germania (147), in Francia (127) e in Lettonia (69) [10] (figure 7,8).
Figura 7. Casi di difterite (C. diphtheriae e C. ulcerans tossigeni), per anno, riportati nei Paesi europei dal 2010 al 2021 (fonte: ECDC)

Figura 8. Numero di casi di difterite da C. diphtheriae e da C. ulcerans tossigeni riportati nei Paesi europei dal 2010 al 2021 (fonte: ECDC)

In un rapporto del 2021, l’European Centre for Disease Prevention and Control (ECDC), descrive l’andamento e le caratteristiche clinico epidemiologiche dei 63 casi di difterite notificati in Europa nel 2018 [11]:
- Sono attribuiti a C. diphtheriae 29 casi e a C. ulcerans 33 casi, mentre in un caso l'agente patogeno non è stato specificato
- Il tasso di notifica complessivo è stato 0,1 per milione di abitanti
- La difterite da C. diphtheriae è stata segnalata in nove paesi: Germania (7), Regno Unito (5), Francia, Lettonia e Svezia (4), Paesi Bassi (2), Norvegia, Slovacchia e Spagna (1)
- I casi da C. ulcerans sono stati segnalati in sei paesi: Germania (19), Francia e Regno Unito (5), Belgio (2), Italia e Svezia (1)
- Sono presenti casi in tutte le fasce di età, maggiormente tra i soggetti di età compresa tra 45 e 64 anni (32%) e più di 65 anni (38%)
- Il 73% casi sono nel genere maschile
- In 25 dei 29 casi da C. diphtheriae era nota la presentazione clinica: 2 con difterite respiratoria classica, 2 con infezione respiratoria senza membrana, 18 con infezioni cutanee (di cui 15 segnalati come importati)
- Dei 33 casi da C. ulcerans, 25 avevano un'infezione cutanea, 2 difterite respiratoria classica e 1 presentava infezione respiratoria senza membrana
- Dei casi di C. diphtheriae 6 erano dovuti al biovar gravis e 5 al biovar mitis; per 18 casi di C. diphtheriae il biotipo era sconosciuto
- Le informazioni sull'esito erano disponibili solo per 58 casi. Un decesso è stato segnalato a causa del biotipo C. diphtheriae var gravis in un uomo di 87 anni in Lettonia.
Nel casi del 2018, diciotto sono stati segnalati come importati o correlati all'importazione. Tutti i casi importati sono stati causati da C. diphtheriae. Il probabile paese di origine era noto per 14 casi: Ghana (1), Guinea (1), India (1), Kenya (1), Sri Lanka (1), Mali (1), Myanmar (1), Filippine (2), Somalia (2), Thailandia (2) e Tanzania (1). Undici casi confermati di C. diphtheriae sono stati segnalati come indigeni: Lettonia (4), Francia (2), Germania (1), Paesi Bassi (1), Slovacchia (1), Spagna (1) e Regno Unito (1). Non sono stati registrati casi importati dovuti a C. ulcerans.
L’ufficio regionale per l'Europa dell'OMS (WHO Europe), in un recente rapporto riepiloga la situazione nell’area di competenza dal 2012 al 2022 [12,13]. Secondo questo documento, nel 2022 è stato segnalato un numero insolitamente elevato di casi di difterite, la maggior parte dei quali si è verificata nel periodo giugno-ottobre: si tratta di 391 casi segnalati da nove paesi (Austria, Rep. Ceca, Francia, Germania, Italia, Paesi Bassi, Norvegia, Svizzera e Regno Unito). Di questi, 272 (70%) sono stati confermati in laboratorio come difterite tossigena: 241 da C. diphtheriae e 31 da C. ulcerans. Il 74% (202 casi) è stato classificato come difterite cutanea, in 6 casi la diagnosi era difterite respiratoria classica. Sono stati accertati 4 decessi.
Nell’intera casistica (391), 74 soggetti (19%) erano residenti locali, con 7 casi di infezione acquisita in viaggi all’estero, mentre in 317 (81%) si trattava di richiedenti asilo, rifugiati o altri migranti appena arrivati, principalmente originari dell'Afghanistan (169 casi) o di altri Paesi, inclusi Algeria, Bangladesh, Camerun, Iran, Iraq, Marocco, Pakistan, Federazione Russa, Siria, Tunisia e Turchia.
Il 6 ottobre 2022, l’ECDC ha pubblicato un Rapid Risk Assessment, rappresentando l’incremento dei casi di difterite da C. diphtheriae in Europa, nella popolazione immigrata [14]. Sette paesi europei avevano segnalato 92 casi di difterite tra i migranti dal primo gennaio al 26 settembre 2022: Germania (31), Svizzera (24), Austria (17), Francia (6), Norvegia (6), Regno Unito (5) e Belgio (3). La media annuale dei casi segnalati all’ECDC in tutta l’UE/AEE tra 2016 e 2020 era 52 casi all'anno (circa il 50% di questi dovuto a C. diphtheriae). La maggior parte dei casi erano di nazionalità afgana (38), seguiti da siriani (17), marocchini (2), tunisini (2), bengalesi (1), indiani (1), liberiani (1), turchi (1) e un cittadino UE/AEE. La copertura del vaccino DTP3 nel 2021 in Afghanistan (66%) e Siria (48%) è attualmente molto bassa, come riportato dalle stime di OMS e UNICEF.
La maggior parte delle diagnosi è stata fatta nei centri di accoglienza. Sessantasei di questi casi presentavano difterite cutanea causata da C. diphtheriae. Sono stati segnalati anche casi di difterite respiratoria, compreso un caso fatale. Inoltre, è stato rilevato un caso di difterite cutanea in un membro del personale di un centro di accoglienza in Svizzera.
Il numero di casi segnalati finora nel 2022 rappresenta un aumento rispetto alla media casi importati osservati negli ultimi anni. Questo potrebbe essere spiegato da un aumento del volume di migranti provenienti da paesi dove la difterite è endemica, da una maggiore circolazione dell'agente patogeno nei paesi di origine o da un incremento del rischio di trasmissione in contesti specifici come i centri di accoglienza per migranti.
L’analisi genetica ha rivelato la presenza di tre diversi sequence type (ST): ST377, ST384 e ST574: l'indagine ha mostrato che ciascuno dei ST riportati costituisce un cluster. La rilevanza di questa osservazione per la salute pubblica è oggetto di investigazione, con la raccolta di informazioni epidemiologiche.
L'ECDC non ha rilevato focolai dovuti all'aumento dei casi importati nella popolazione europea. Il rischio di contrarre la difterite per la comunità è ritenuto molto basso per chi ha completato il ciclo vaccinale. Si stima un rischio moderato per non vaccinati o immunodepressi che vivono o lavorano in centri di accoglienza.
Il rapporto ECDC della sorveglianza sulle malattie diffusibili del 23-29 ottobre 2022 riporta ulteriori segnalazioni di casi nei migranti [15].Tra questi, sono presenti tre casi di C. diphtheriae tossigeno trasmessi il 20 ottobre dalle autorità sanitarie italiane: due con forme cutanee e uno con una malattia cutanea e respiratoria. Tutti i casi sono stati ricoverati in ospedale con lesioni cutanee e un caso presentava febbre e faringite acuta senza formazione di pseudomembrane. Si tratta di rifugiati maschi, di età compresa tra 35 e 44 anni, arrivati in Italia tra agosto e ottobre da Bangladesh, Pakistan e Turchia.
L’ultimo rapporto pubblicato dall’ECDC è aggiornato al 10 gennaio 2023 (settimana 2/2023) [16]. I casi riportati in migranti dall'inizio del 2022 sono 331: Germania (116), Regno Unito (73), Austria (63), Belgio (25), Svizzera (25), Francia (14), Norvegia (7) Paesi Bassi (5), Italia (2) [17] e Spagna (1) (figura 9). Tra questi, la maggioranza dei casi (230) presentava la forma cutanea, 46 la respiratoria, 6 malattia respiratoria e cutanea, 30 erano asintomatici, mentre per 19 casi mancavano informazioni. In tutti i casi l’agente eziologico era C. diphtheriae tossigeno, per la maggior parte sono stati colpiti maschi, di età compresa tra 8 e 49 anni.
Figura 9. Casi di difterite in migranti nei Paesi europei dall’inizio del 2022 al 10/1/2023 (settimane 1/2022- 2/2023, fonte: ECDC)

Un recente articolo su Eurosurveillance descrive le caratteristiche dei casi di difterite importati in Germania [18]. In questo lavoro si è rilevato che tutti gli isolati ST-377 (5 casi) erano fenotipicamente resistenti all'eritromicina e alla clindamicina. Questo dato conferma i risultati di una precedente pubblicazione relativa ai casi di migranti in Svizzera [19]. In aggiunta, la ricerca di geni di resistenza ha rilevato, tra gli altri, geni per la resistenza contro macrolidi/lincosamidi e beta-lattamici (ermX, OXA-2).
La tipizzazione molecolare ad alta risoluzione di C. diphtheriae è indispensabile per identificare le trasmissioni della malattia e le epidemie. Nel corso degli anni, sono stati impiegati molti metodi per la genotipizzazione: dalla tipizzazione del ribotipo di una ventina di anni fa, a metodi basati sulla PCR, al MultiLocus Sequence Typing (MLST), sino ad approdare al Whole Genome Sequencing (WGS), ovvero al sequenziamento e all’analisi dell’intero genoma batterico, come parte integrante dei programmi di sorveglianza [3].
7. In prospettiva
Un tempo la difterite rappresentava una delle principali cause di mortalità infantile e di ospedalizzazione in età pediatrica. In diversi ospedali pediatrici era presente un sistema di allarme acustico interno per far accorrere i medici quando un bambino rischiava di soffocare a causa del croup. L'estensione globale delle campagne vaccinali ha fatto crollare i casi da oltre un milione all’anno (metà del ventesimo secolo) a 5-10.000.
La difterite non è più considerata una grave minaccia per la salute pubblica ed è stata in gran parte dimenticata, con conseguente diminuzione del livello di attenzione, di conoscenza e delle capacità diagnostiche in molte istituzioni.
Negli anni Novanta, in Europa orientale un’epidemia di durata decennale causò 157.000 casi e 5.000 morti. In tempi più recenti ci sono state epidemie in molte parti del mondo, spesso associate a disordini politici: 8.640 casi con 45 morti a Kutupalong (Bangladesh, 2017-2019); 1.904 casi sospetti con 164 morti in Venezuela e 808 casi probabili con 107 morti ad Haiti (2018); 1.907 casi sospetti con 98 morti in Yemen (2018).
Un articolo di Science del 2017 denunciava la diminuzione delle scorte globali di antitossina difterica, a causa dell'interruzione della produzione, a sua volta dovuta alla riduzione della domanda.
Queste epidemie sottolineano la necessità di rinnovare gli sforzi per comprendere meglio la difterite e migliorare le strategie di risposta dei sistemi sanitari. L'aumento dei casi segnalati in Europa nella popolazione immigrata è ritenuto meritevole di attenzione dall’ECDC, e deve essere monitorato; inoltre sono necessarie misure di sanità pubblica per evitare la diffusione.
È necessario il retraining del personale medico e un aggiornamento delle capacità diagnostiche che devono essere in grado di rispondere tempestivamente e con competenza a quesiti clinici spesso aspecifici.
La probabilità di sviluppare la malattia è molto bassa per la popolazione generale, se la copertura vaccinale con cicli completi è elevata e lo stato di immunizzazione aggiornato. Tuttavia, la possibilità di infezioni secondarie nella comunità non può essere esclusa e la difterite grave è possibile in soggetti non vaccinati o immunodepressi, con particolare attenzione a chi lavora nei centri di accoglienza per migranti.
Determinati sequence type mostrano un profilo genomico indicativo di resistenza antimicrobica. Sono necessarie ulteriori valutazioni per le implicazioni potenziali di queste osservazioni, compreso l'adattamento dei regimi di trattamento antibiotico attualmente indicati.
L’ECDC raccomanda una serie di azioni, in risposta all’incremento di casi rilevato in Europa, nella popolazione migrante, come riportato nella tabella seguente.
| » identificazione e vaccinazione delle persone residenti nei centri per migranti con stato vaccinale incompleto |
| » informazioni agli operatori dei centri per migranti, per la rapida identificazione e isolamento di possibili casi in attesa di conferma diagnostica |
| » attuazione di precauzioni per la diffusione da droplets in tutti i casi confermati o sospetti di difterite respiratoria |
| » precauzioni da contatto per casi confermati e sospetti di difterite cutanea |
| » isolamento di tutti i casi confermati (presentazione respiratoria e cutanea) fino a dimostrazione dell'eliminazione del microrganismo (due colture negative ottenute ad almeno 24 ore di distanza dopo il completamento del trattamento antimicrobico) |
| » tracciamento dei contatti stretti, compresi gli operatori sanitari, soprattutto se hanno operato senza adeguati dispositivi di protezione individuale |
| » profilassi antimicrobica post-esposizione e vaccinazione di contatti stretti non completamente vaccinati o non vaccinati |
| » allertare i medici sulla difterite cutanea e respiratoria tra migranti e viaggiatori di ritorno da aree endemiche |
| » raccolta di dati sul Paese di origine e sulla rotta migratoria di tutti i casi sospetti di difterite |
| » aggiornamento dello stato vaccinale per tutto il personale che opera nei centri di accoglienza per migranti |
| » limitazione dell'affollamento nei centri per migranti |
| » verifica della disponibilità di laboratori diagnostici in ciascun Paese |
| » segnalazione tempestiva alle autorità dei casi confermati |
| » sorveglianza, compresa la tipizzazione molecolare e il sequenziamento dell'intero genoma degli isolati, per migliorare la comprensione e il monitoraggio dei modelli di diffusione |
Articolo a cura di:
- Simona Barnini, Rete SMART, Direttore SD Microbiologia batteriologica AOUP
- Fabrizio Gemmi, ARS Toscana, Coordinatore Osservatorio per la Qualità ed Equità
Bibliografia
- CDC. Diphtheria (pagina web visitata il 27 dicembre 2022)
- Manuale MSD. Difterite (pagina web visitata il 27 dicembre 2022)
- Sharma NC, Efstratiou A, Mokrousov I, Mutreja A, Das B, Ramamurthy T. Diphtheria. Nat Rev Dis Primers. 2019 Dec 5;5(1):81. doi: 10.1038/s41572-019-0131-y. PMID: 31804499.
- Holbourn, K.P., Shone, C.C. and Acharya, K.R. (2006). A family of killer toxins. The FEBS Journal, 273: 4579-4593. https://doi.org/10.1111/j.1742-4658.2006.05442.x
- Nicolai G, Porchia B, Bonanni P, Capolongo A (2017). Vaccino DTPa (difterite-tetano-pertosse acellulare).
- WHO (2017). Diphtheria vaccine: WHO position paper – August 2017.
- WHO. Immunization, Vaccines and Biologicals. Diphtheria (pagina web visitata il 27 dicembre 2022)
- WHO. Diphtheria reported cases and incidence (pagina web visitata il 29 dicembre 2022)
- Truelove SA, Keegan LT, Moss WJ, Chaisson LH, Macher E, Azman AS, Lessler J. Clinical and Epidemiological Aspects of Diphtheria: A Systematic Review and Pooled Analysis. Clin Infect Dis. 2020 Jun 24;71(1):89-97. doi: 10.1093/cid/ciz808.
- ECDC. Surveillance Atlas of Infectious Diseases (dati scaricati il 22 dicembre 2022)
- ECDC. Diphtheria. Annual epidemiological report for 2018. Surveillance Report, 3 Feb 2021
- La Regione europea dell’OMS comprende 53 Stati, ed è quindi molto più ampia dell’area geografica descritta nei rapporti ECDC
- WHO, 19 January 2023. Vaccine-preventable disease update: reported diphtheria cases in the WHO European Region, 2022
- EDCD, 6 October 2022. Increase of reported diphtheria cases among immigrants in Europa due to Corynebacterium diphtheriae, 2022.
- ECDC. Weekly Communicable Disease Threats Report, Week 43. 28 October 2022
- ECDC. Weekly Communicable Disease Threats Report, Week 2. 13 January 2023
- Nei rapporti ECDC delle settimane 48 e 49, per l’Italia sono riportati 3 casi, mentre dalle edizioni seguenti sono riferiti solo 2 casi, perché in 1 dei 3 la produzione di tossina non è stata confermata dall’ISS
- Badenschier F, et al. Outbreak of imported diphtheria with Corynebacterium diphtheriae among migrants arriving in Germany, 2022. Euro Surveill. 2022 Nov;27(46):2200849. doi: 10.2807/1560-7917.
- Kofler J, et al. Ongoing toxin-positive diphtheria outbreaks in a federal asylum centre in Switzerland, analysis July to September 2022. Euro Surveill. 2022 Nov;27(44):2200811. doi: 10.2807/1560-7917.
- Kupferschmidt K. Life-saving diphtheria drug is running out. Science 2017; 355:118–9.
